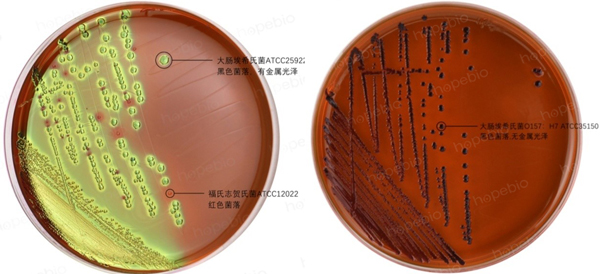
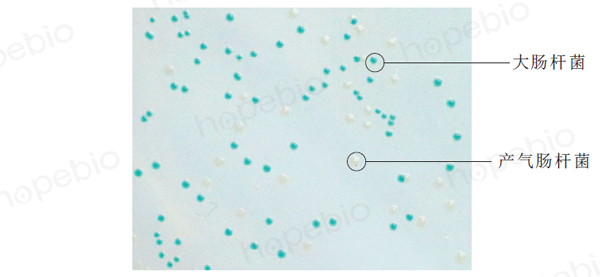
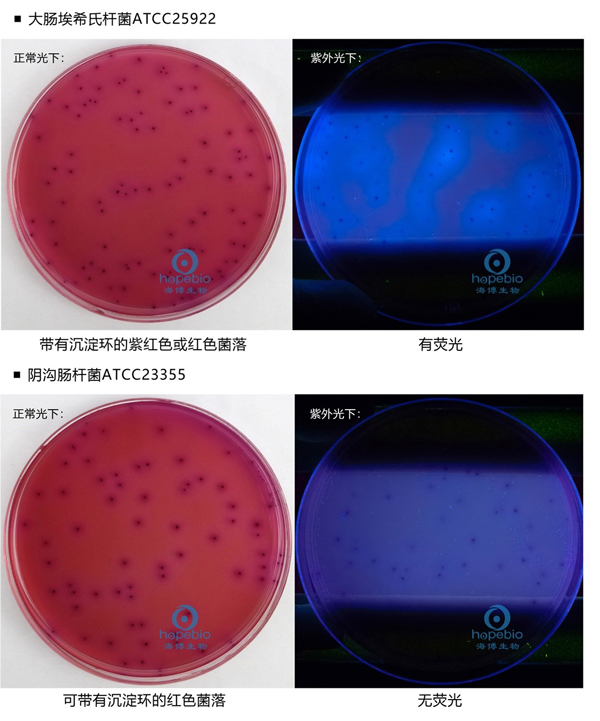

海博微信公众号
海博天猫旗舰店




1.LB琼脂:
此培养基为非选择性固体培养基,常用于分子生物学中大肠杆菌的培养,也可用于大肠杆菌活化和纯菌计数。可在培养基用加入对应的抗生素(如青霉素、四环素、卡那霉素等)进行特定转基因大肠杆菌的筛选。
2.伊红美蓝琼脂(EMB):
此培养基为弱选择性培养基,不仅适用于大肠杆菌的分离培养和计数,也适用于大肠菌群的分离培养。大肠杆菌由于强烈发酵乳糖产酸,菌落通常为紫黑色,带有绿色金属光泽(也有一些大肠杆菌菌落不带金属光泽),大肠菌群发酵乳糖产酸稍弱,菌落通常为红色或粉红色,无金属光泽,不发酵乳糖的其他肠道菌通常为无色或淡红色菌落。因分离效果较弱,此培养基更常用于大肠杆菌或大肠菌群多管发酵法中阳性管的确认。
3.麦康凯琼脂:
检验分离肠道菌最常用的培养基,在药典中用于大肠杆菌的检测,在食品标准用于肠道致病菌的分离。培养基中较多的胆盐及结晶紫对大多数革兰氏阳性菌有很强的抑制效果,大肠杆菌由于强烈发酵乳糖产酸,在培养基上菌落为桃红色,并且菌落周围通常有明显的沉淀环,大肠菌群同样能发酵乳糖产酸,菌落也为桃红色,致病性的肠道菌则通常因不发酵乳糖(如志贺氏菌、沙门氏菌、变形杆菌等)菌落呈无色。此培养基由于对大肠杆菌的专一性较弱(大肠菌群和大肠杆菌的菌落特征比较接近),若样品中大肠菌群的含量比较高,分离大肠杆菌的效果并不理想。

4.大肠杆菌显色培养基/TBX培养基:
利用酶底物法原理,对于大肠杆菌的分离和计数有高度的特异性,大肠杆菌特有的β-葡萄糖醛酸苷酶可分解培养基中的底物,使菌落呈蓝绿色,而大肠菌群和其他大多数杂菌通常为无色或其他颜色,革兰氏阳性菌大多数不生长。特别是在干扰菌较多的情况下,显色培养基的分离率要远高于其他的培养基,缺点是价格较高,还有极少数大肠杆菌不产生β-葡萄糖醛酸苷酶,不能显色(如肠出血性大肠埃希氏菌O157菌)。此培养基适用范围较广,食品、水、环境等均可检测。
5.哥伦比亚MUG培养基/MUG营养琼脂:
原理与显色培养基相同,大肠杆菌可利用β-葡萄糖醛酸苷酶特异性分解MUG,在紫外灯下产生荧光,特异性较强,极少数不产生β-葡萄糖醛酸苷酶的大肠杆菌不产荧光。但此培养基没有选择性,多数杂菌都能生长,因此通常只用于含菌量较少的水中大肠杆菌计数。

6.VRBA-MUG培养基:
在VRBA基础上添加了MUG,相比较于哥伦比亚MUG培养基,VRBA-MUG培养基具有选择性,可抑制革兰氏阳性菌的生长,大肠杆菌和大肠菌群可在此培养基中生长呈紫红色菌落,周围有沉淀环,由于添加了MUG,在紫外灯下照射时,大肠杆菌菌落可有荧光反应,而大肠菌群则没有荧光。此培养基一般用于食品中大肠杆菌的检验和计数。
相关产品:
结晶紫中性红胆盐-4-甲基伞形酮-β-D-葡萄糖苷琼脂(VRBA-MUG)-点击查看产品详情
注:本文属海博生物原创,未经允许不得转载。
上一篇:常用染料的溶解方法和注意事项
下一篇:微生物试验用菌的挑选及注意事项
